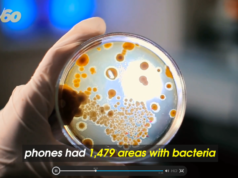

- AAA
- Accuweather.com
- Addiction
- Alzheimers/Dementia
- Amazon
- American Jewish Committee
- Animals
- APNews.com
- Articles
- Artificial Intelligence
- ATF
- Auctions
- Audio
- Audio Only
- Automobiles
- AXIOS.com
- Bankrate.com
- Bankruptcy
- Bloomberg.com
- Boating
- BrowardBeat.com
- BSO
- Business
- BusinessInsider.com
- BusinessTravelerUSA.com
- BusinessWire.com
- C-SPAN.com
- Cancer
- CandyStore.com
- Cannabis
- CapitolSoup.com
- CBD
- CDC
- CFPB (Consumer Financial Protection Bureau)
- Chad Van Horn
- CIA
- Cleveland Clinic
- CNBC.com
- CNET.com
- CNN
- CNTraveler.com
- Commentary
- Computer
- Consumer
- ConsumerReports.com
- Coronavirus
- COVID
- CPI
- CPSC
- Credit Cards
- Credit Check
- Crime
- Cryptocurrency
- Cuba
- cyber security
- DailyBusinessReview.com
- Debt
- DefenseScoop
- DEI
- Delish.com
- Der Spiegel
- DHS
- Diabetes
- DOD
- DOGE
- DOJ
- Drive-thru
- Drone
- Drugs
- E-bikes
- EarthTalk.org
- eCommerce
- EdScoop.com
- Education
- Election
- Electric vehicles
- Employment
- Engineering
- Entertainment
- Entrepreneurs
- Environmental
- EPA
- ERI
- Exclusive
- Exercise
- FAA
- FamilyFeatures.com
- FBI
- FCC
- FDA
- FDLE.state.fl.us
- FEMA
- FHP
- Financial
- Fishing Charters
- FishingBooker.com
- Florida Keys News Bureau
- FloridaBulldog.org